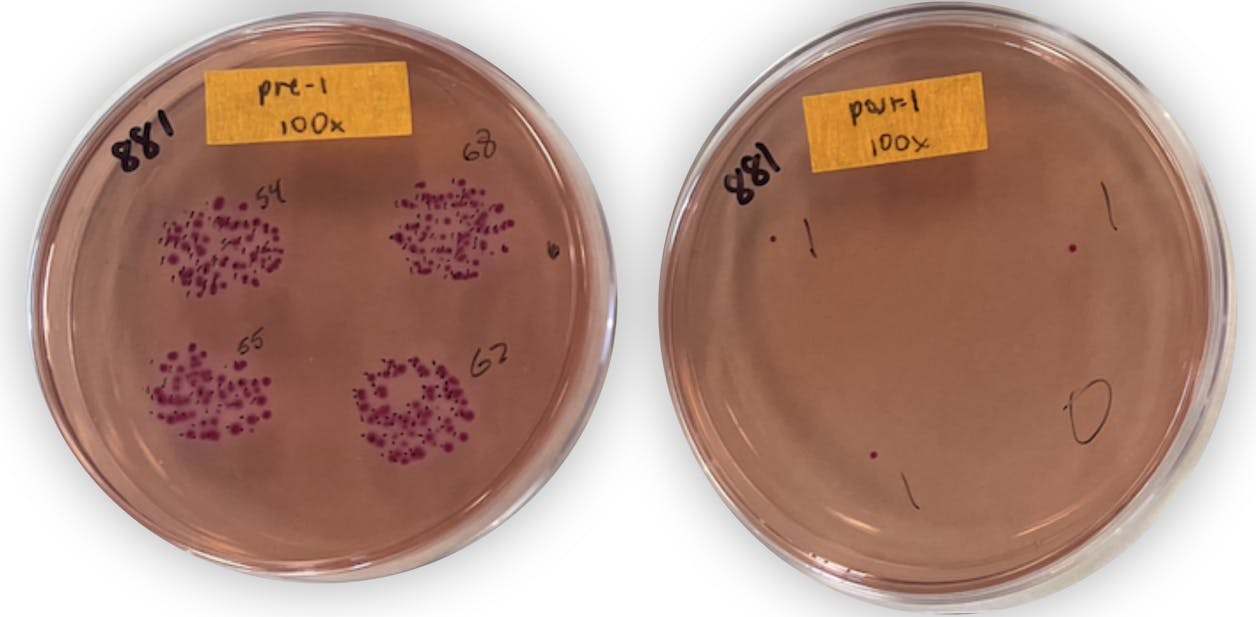
2 Petri dishes side by side, with more bacteria in the left one, and less on the right

A glow-up, in the name of science
By Monique Kleinhuizen '08, GS'16, content specialist
December 03, 2025 | Noon

It’s common knowledge that frequent and thorough hand-washing is one of the best ways to slow the spread of germs and viruses. And yet, the general public’s hygienic habits aren’t quite up to par. With the COVID-19 pandemic not far enough in the rear-view mirror, and in partnership with tech start-up incubator Minnetonka Labs, a student-faculty research team from the Department of Chemistry and Biochemistry has created a way to make hand-washing more visual and effective.
In 2020, Professor of Chemistry James Christenson was approached by a friend at Minnetonka Labs, where a team of engineers was developing a glow soap faucet system with a black light that causes hand soap to glow. One of the lab’s founders was inspired by an unfortunate dining experience where he saw a fast food employee leave a restroom without washing his hands. He thought that making hand-washing more memorable—and even fun—might entice people to do it more consistently and thoroughly.
The faucet itself was well underway, but the team didn’t have a glow soap formulated, so they asked Christenson to build a team of student researchers and complete a two-part project. First, they’d formulate a hand soap that would “pop and glow” under the faucet blacklight, Christenson explains. Then, they’d carry out an experiment to quantify the effectiveness of a glow soap faucet system at removing bacteria—compared to run-of-the-mill faucets.
Christenson enlisted Liana (Johnson) Kubas ’23, Abbie Swenson ’24, and Signe (Penn) Kopp ’23 to support the project in 2021 and 2022, with stipends paid through the department’s summer research endowment and using the Nelson-Larson Science Center. The project was clear, but wasn’t without some logistical challenges.
First, they had to come up with a glowing soap. They needed ingredients that were not only effective, but safe, legal, affordable, and biodegradable. Christenson remembers literally paging through the Food and Drug Administration’s comprehensive list of all approved substances that could be used in a hand soap. The team tested combination after combination, washing their hands with each test substance. “There were definitely some days my hands came home pink or orange because some colored substance didn’t wash out,” Christenson remembers.
“One of the funniest moments was trying to figure out how to get bacteria off people’s hands to test and measure it,” Christenson recalls. “It turns out that when you put on a surgical glove, and then put some liquid in there, the bacteria come into the liquid. However, we needed to do that process in a consistent way, so we literally bought hand massagers. After washing, we’d put on this surgical glove with liquid in it, stick it down into a hand massager and complete a one-minute massage. Hand massagers are definitely my oddest research purchase ever!”
After each handwash, bacteria were extracted using the glove and the liquid was plated onto petri dishes. The bacteria grew overnight on the petri dishes and could be counted by hand the next morning. The impact was clear, with 3.1 times fewer bacteria remaining on hands when using a glow soap faucet compared with standard washes. The team landed on a soap formula that was both visually striking and effective.
While the data spoke for itself, the team knew sentiment and buy-in would be important in getting the product out into the world. Those in leadership at schools and workplaces would need to value the impact enough to invest in a new product for their community. Christenson and Minnetonka Labs formed a collaboration with the healthcare community at Regions Hospital to test the glow soap faucet. When one was placed in Regions’ medical training facilities, reception was overwhelmingly positive. Ninety-three percent of polled healthcare workers said the setup would “probably” or “definitely” decrease infection rates in a workplace like theirs.
These studies became the basis of a scholarly article, “New shine on an old habit: a pilot study on a glow soap faucet system,” which was published this fall in the Journal of Hospital Infection.
— Signe (Penn) Kopp ’23
One of the student researchers, Kopp, majored in biology, biochemistry, and chemistry at Bethel and is now pursuing a Ph.D. in cell and developmental biology at the Medical College of Wisconsin. She was part of a number of student-faculty research projects during her time at Bethel, and she says experiences like this one opened her mind to all the possibilities open to her—and helped her graduate school application stand out.
“I realized I love the creativity and the brainstorming required to do science well. It's one of my favorite parts of doing research today: coming up with a crazy idea, searching articles to see what could be possible, and then designing your own experiments to see what is true,” Kopp says. “I love that process of discovery, and I'm really thankful that I learned this in undergrad. I was encouraged to have independence in my projects, and this really helped me grow as a scientist.”
She describes the unique research environment at Bethel, with summer brainstorming sessions happening between faculty and student researchers. There didn’t seem to be a hierarchy; everyone was simply bringing their best ideas for the good of the project. They’d all gather around a whiteboard, taking turns scribbling down ideas.
“It was such a collaborative environment, and our ideas were taken seriously,” she says. Today, she and the other recent alumni who were part of this project watch from afar as Minnetonka Labs explores the marketability of the GSFS and the glowing soap in a variety of sectors. She remains in contact with fellow alumni and faculty mentors and is grateful for the impact the network has had on her learning and career.
“Even when we were struggling to get an experiment to work, we were still having fun troubleshooting together,” she says. “I really love that I was given independence in the lab, and that we were trusted to have significant contributions. It helped grow my confidence as a scientist.”
Study chemistry and biochemistry at Bethel
Get the support, space, and tools you need to pursue answers to important questions—and launch a successful career in the sciences.